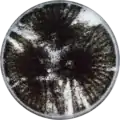
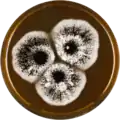

Aspergillus costaricaensis
Aspergillus costaricaensis is a species of fungus in the genus Aspergillus. A. costaricaensis belongs to the group of black Aspergilli that are used in industry to create enzymes and other products.[2][3][4] A. costaricaensis belongs to the Nigri section. The species was first described in 2004.[1] It has been found in soil in Gaugin Garden on Taboga Island, Costa Rica. It produces large pink to greyish brown sclerotia.[1]
| Aspergillus costaricaensis | |
|---|---|
| Scientific classification | |
| Kingdom: | Fungi |
| Division: | Ascomycota |
| Class: | Eurotiomycetes |
| Order: | Eurotiales |
| Family: | Trichocomaceae |
| Genus: | Aspergillus |
| Species: | A. costaricaensis |
| Binomial name | |
| Aspergillus costaricaensis Samson & Frisvad (2004)[1] | |
The genome of A. costaricaensis was sequenced and published in 2014 as part of the Aspergillus whole-genome sequencing project – a project dedicated to performing whole-genome sequencing of all members of the genus Aspergillus.[5] The genome assembly size was 36.95 Mbp.[5]
Growth and morphology
Aspergillus costaricaensis has been cultivated on both Czapek yeast extract agar (CYA) plates and Malt Extract Agar Oxoid® (MEAOX) plates. The growth morphology of the colonies can be seen in the pictures below.
Aspergillus costaricaensis growing on CYA plate
Aspergillus costaricaensis growing on CYA plate Aspergillus costaricaensis growing on MEAOX plate
Aspergillus costaricaensis growing on MEAOX plate
References
- Samson, R. A. New ochratoxin A or sclerotium producing species in Aspergillus section Nigri. Studies in Mycology 2004, 50, 45–61.
- Pel, H. J.; de Winde, J. H.; Archer, D. B.; Dyer, P. S.; Hofmann, G.; Schaap, P. J.; Turner, G.; de Vries, R. P.; Albang, R.; Albermann, K.; Andersen, M. R.; Bendtsen, J. D.; Benen, J. A. E.; van den Berg, M.; Breestraat, S.; Caddick, M. X.; Contreras, R.; Cornell, M.; Coutinho, P. M.; Danchin, E. G. J.; Debets, A. J. M.; Dekker, P.; van Dijck, P. W. M.; van Dijk, A.; Dijkhuizen, L.; Driessen, A. J. M.; d’Enfert, C.; Geysens, S.; Goosen, C.; Groot, G. S. P.; de Groot, P. W. J.; Guillemette, T.; Henrissat, B.; Herweijer, M.; van den Hombergh, J. P. T. W.; van den Hondel, C. A. M. J. J.; van der Heijden, R. T. J. M.; van der Kaaij, R. M.; Klis, F. M.; Kools, H. J.; Kubicek, C. P.; van Kuyk, P. A.; Lauber, J.; Lu, X.; van der Maarel, M. J. E. C.; Meulenberg, R.; Menke, H.; Mortimer, M. A.; Nielsen, J.; Oliver, S. G.; Olsthoorn, M.; Pal, K.; van Peij, N. N. M. E.; Ram, A. F. J.; Rinas, U.; Roubos, J. A.; Sagt, C. M. J.; Schmoll, M.; Sun, J.; Ussery, D.; Varga, J.; Vervecken, W.; van de Vondervoort, P. J. J.; Wedler, H.; Wösten, H. A. B.; Zeng, A.-P.; van Ooyen, A. J. J.; Visser, J.; Stam, H. Genome sequencing and analysis of the versatile cell factory Aspergillus niger CBS 513.88. Nat. Biotechnol. 2007, 25, 221–231, doi:10.1038/nbt1282.
- Goldberg, I.; Rokem, J. S.; Pines, O. Organic acids: old metabolites, new themes. Journal of Chemical Technology & Biotechnology 2006, 81, 1601–1611, doi:10.1002/jctb.1590.
- Pariza, M. W.; Foster, E. M. Determining the Safety of Enzymes Used in Food Processing. Journal of Food Protection 1983, 46, 453–468, doi:10.4315/0362-028X-46.5.453.
- "Home - Aspergillus costaricaensis CBS 115574 v1.0". genome.jgi.doe.gov.